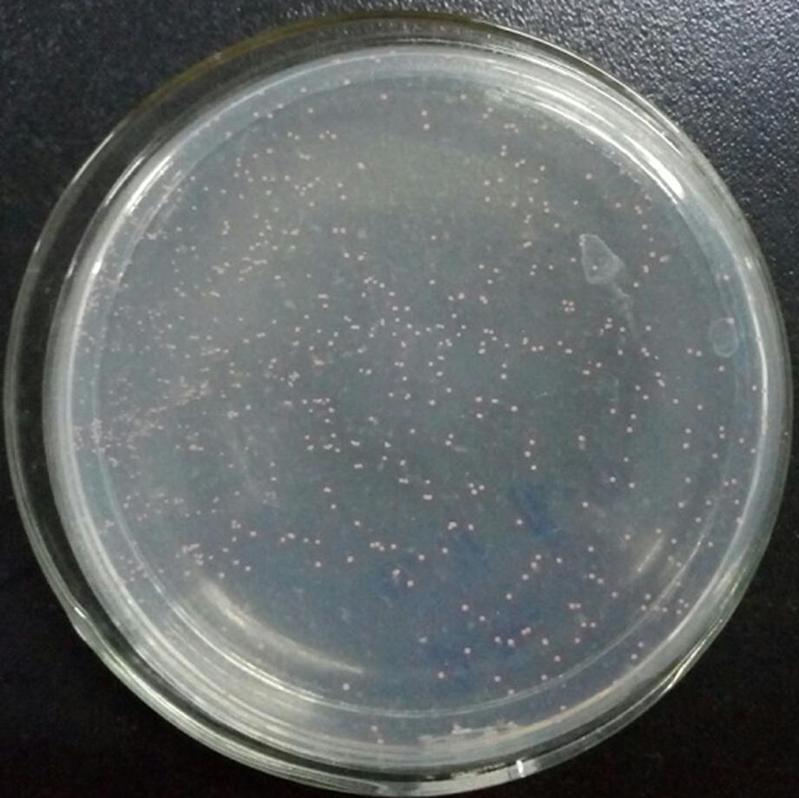

成果名称:基于聚丙烯酸酯废水处理的膜生物反应器关键技术
研发人员:徐文涛
所属领域:海洋化工
完成单位:英国威廉希尔公司官网
成果简介:
由于世界水资源的大量消耗和淡水资源的日益短缺,各国都在积极寻找更为先进的废水再生与回用技术,以解决日益严重的全球水危机。膜生物反应器(MembraneBioreactor,简称MBR)利用现代超微滤膜技术与传统的活性污泥法,创造出一种全新的废水处理技术。
本项目创新出超滤MBR膜片——PVDF(聚偏氟乙烯)超滤,该膜的优点是膜通量高、孔隙率高(>90%)、抗污染、易清洗、寿命长,主要用于污水处理。
本技术通过对聚丙烯酸酯废水中的微生物进行富集、筛选、选育。分离出了对聚丙烯酸酯废水具有强降解作用的2个菌株。实验证明:两株菌混合使用,能使聚丙烯酸酯废水中的COD从1200降到100。对微生物菌与改性的膜技术配合使用证明:改性膜对2株微生物的吸附性能均低于对照10倍左右,减少了对超滤MBR膜片的污染,提高微生物讲解效率,具备与膜片组合开发膜生物专用反应器处理聚丙烯酸酯废水潜力。
技术成熟度:
(1)公开发明专利1项;(2)制备出膜材料2种;(3)分离出具有降解作用的微生物2株。